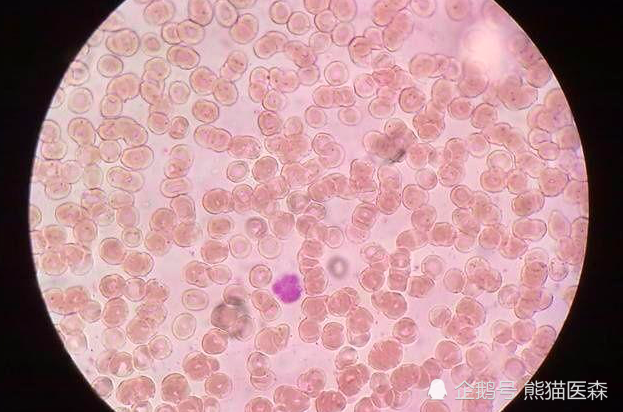
尿常规出现红细胞,别紧张,可能是假象

尿检红细胞

尿检中有新鲜红细胞.
图片尺寸1100x1114
尿液,红细胞,清新,妊娠期糖尿病,尿检样品
图片尺寸1107x1100
一文读懂尿液红细胞形态分析
图片尺寸660x526
尿检中有新鲜红细胞.
图片尺寸1100x1100
尿潜血3 ,红细胞400 ,有必要肾穿吗
图片尺寸1080x1439
一文读懂尿液红细胞形态分析
图片尺寸808x1000
一文读懂尿液红细胞形态分析
图片尺寸731x1000
尿液,红细胞,清新,妊娠期糖尿病,尿检样品
图片尺寸1100x1100
一文读懂尿液红细胞形态分析
图片尺寸799x1000
显微镜,清新,尿检样品,红细胞,水平画幅
图片尺寸1106x1100
尿红细胞形态观察对肾球肾炎的诊断ppt
图片尺寸1080x810
帮忙确认下尿液标本中的红细胞
图片尺寸640x853
尿常规出现红细胞,别紧张,可能是假象
图片尺寸623x412
尿检红细胞的介绍
图片尺寸414x552
尿中异常红细胞,请大家讨论
图片尺寸600x450
尿中异常红细胞请大家讨论
图片尺寸718x539
正常红细胞(sm染色)
图片尺寸622x416
尿沉渣镜检之真假红细胞
图片尺寸468x428
尿中异常红细胞,请大家讨论
图片尺寸600x448
尿液异常红细胞
图片尺寸597x476